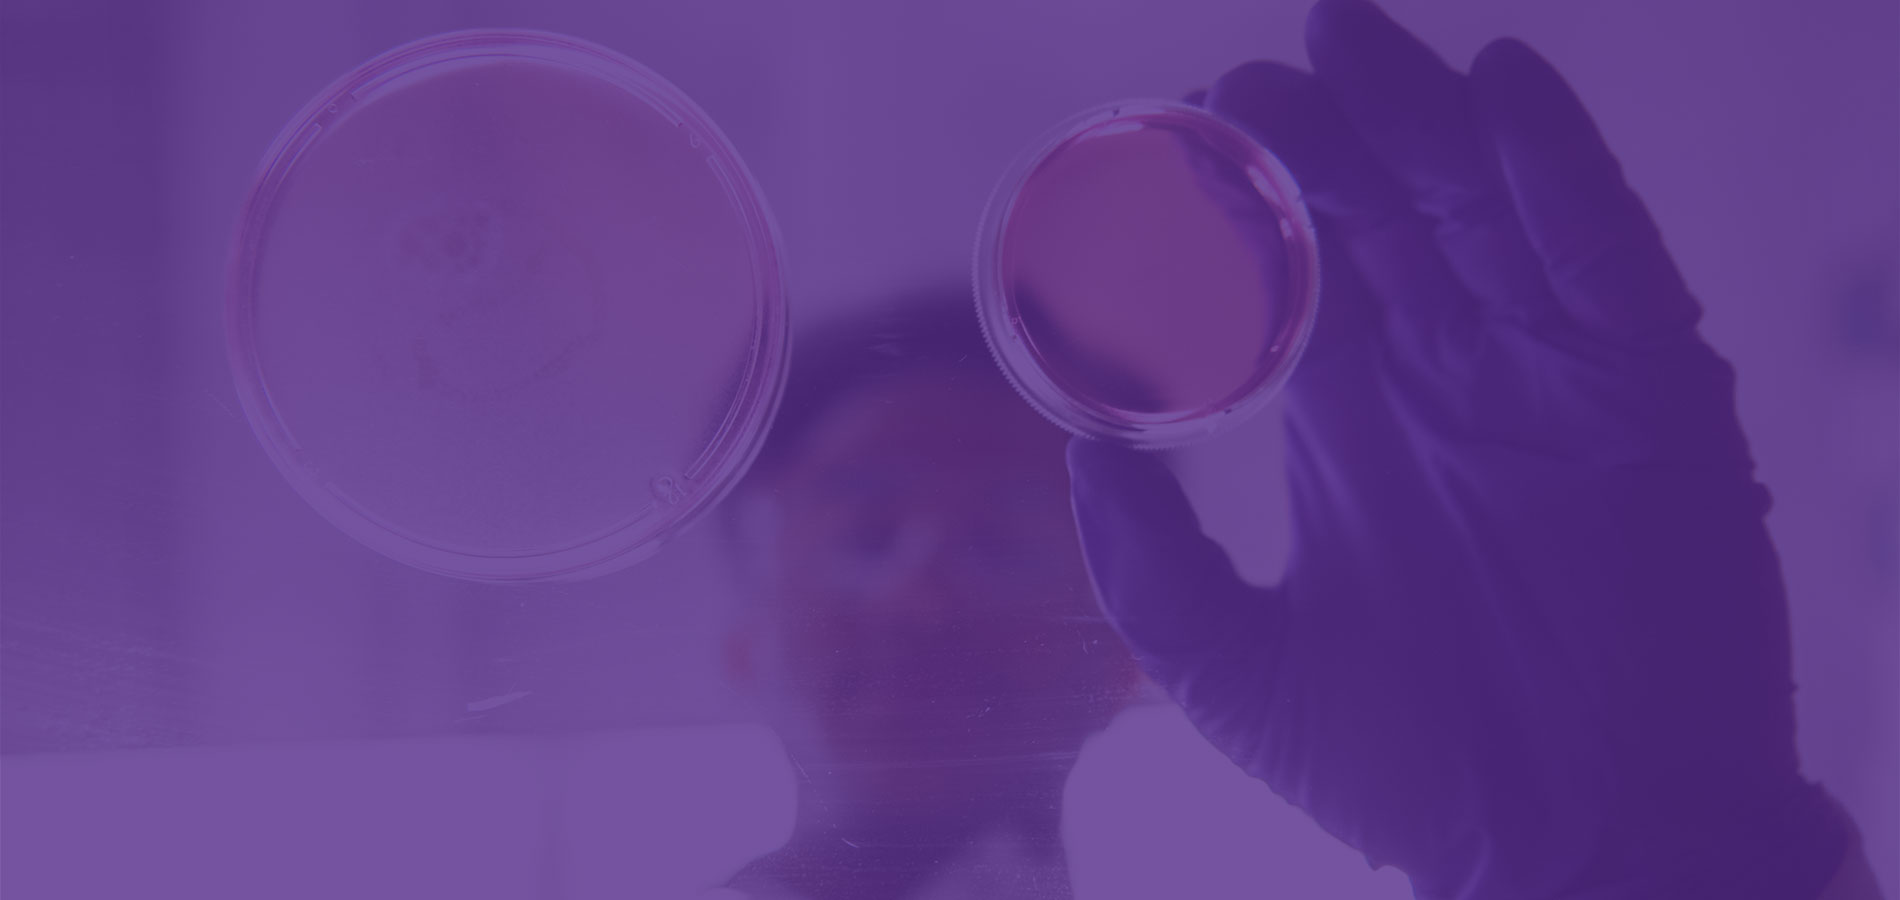

Kansas State University
Leading the nation as the next-generation land-grant university, K-State is the first operational land-grant university in the United States. The home of the Wildcats is setting the standard for inspired learning, creativity, discovery and engagement – positively impacting society and transforming lives in Kansas and around the world.

Explore your interests
Study what you love, connect it to a career and empower yourself to become the best version of you.
-
Request information
Sign up to receive information about degree programs, scholarship opportunities, upcoming events, admission and much more.
Request now -
Apply for admission
Dream big and create the future you want. Start your K-State admission application today!
Apply now -
View scholarships and financial aid
Explore available financial assistance opportunities, including scholarships, grants, loans, work-study and other aid options.
View now -
Visit a K-State campus
K-State is made up of three campuses, each with its own focus, feel and size. With both in-person and virtual visit options, you’re sure to find your fit.
Schedule a visit
Impact in Kansas and Beyond
K-State experts create real-world impact every day. Faculty and researchers inspire learning and discovery while working to solve societal problems locally, nationally and across the world. Read some of today's top stories mentioning Kansas State University.
-
Many farmers, particularly in their operation, that decision may just be a few seconds that they have to make, rather than look at all the possibilities, they just say ‘let me know, is it a green or a red?’
Cotton farmers embracing new technology to boost efficiency – KCBD Jonathan AguilarProfessor, Department of Biological and Agricultural Engineering
Jonathan AguilarProfessor, Department of Biological and Agricultural Engineering
Extension Water Specialist -
There’s been 93% of them that have completed their four-year obligation. More importantly, 15 years going, 83% of them are in rural practice in Kansas today. So they’re staying.
A critical shortage of vets could threaten America’s food supply – InvestigateTV Brad WhiteProfessor, College of Veterinary Medicine
Brad WhiteProfessor, College of Veterinary Medicine
Director, Beef Cattle Institute -
Anxiety tends to swirl in our minds all day, especially when it’s about money. A surprisingly effective strategy is to schedule a daily or weekly ‘worry time’ — 15 to 20 minutes dedicated only to your financial concerns.
This 15-minute weekly habit can help you get better with money, therapist says—here’s how – CNBC Megan McCoyAssociate Professor, School of Consumer Sciences
Megan McCoyAssociate Professor, School of Consumer Sciences
Campus Locations
Our campuses are rich with history and each provide a unique college experience to our students. Kansas State University offers three physical campuses in addition to our online offerings via K-State Online.
-

Manhattan
Our flagship campus established in 1863, rooted in the land-grant mission of educational access and opportunity.
-

Salina
Centered around the student experience emphasizing innovative learning, real-world experiences and industry connections.
-

Olathe
Expanding potential through education, research and engagement in the Greater Kansas City area.